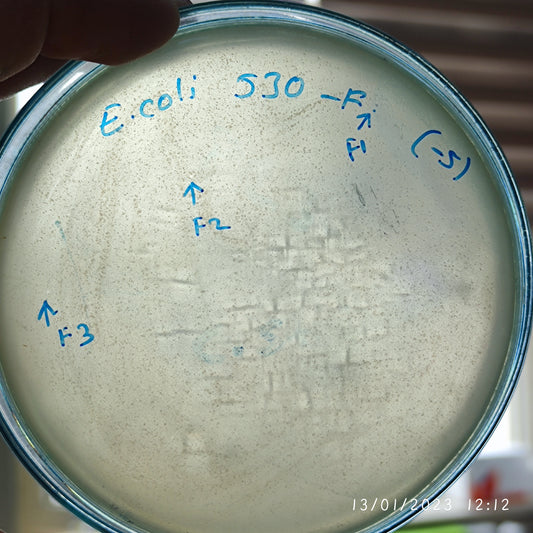
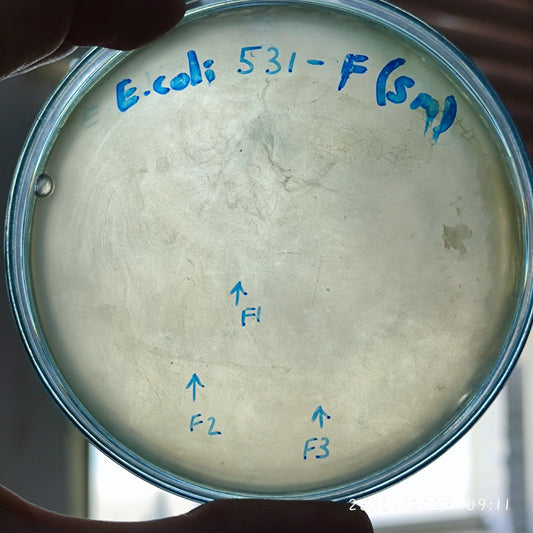
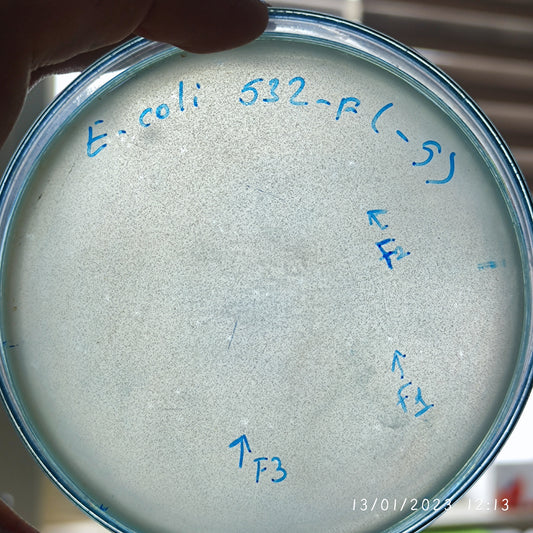
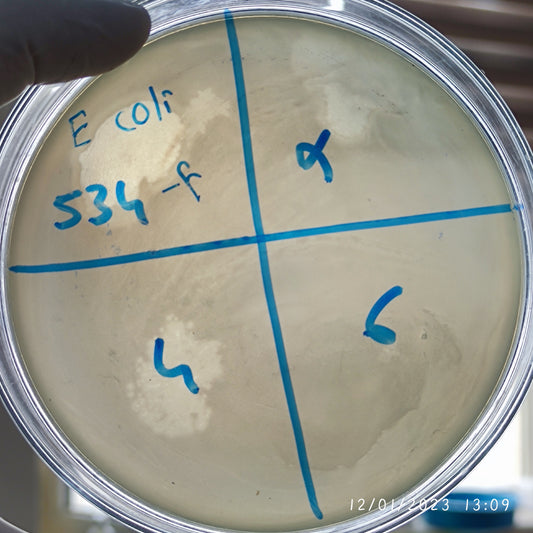
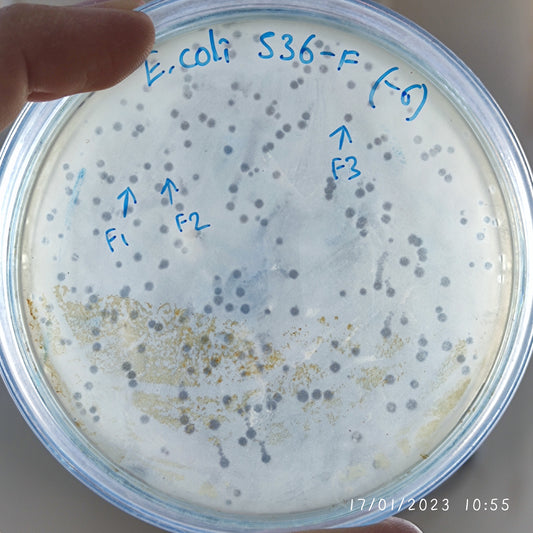
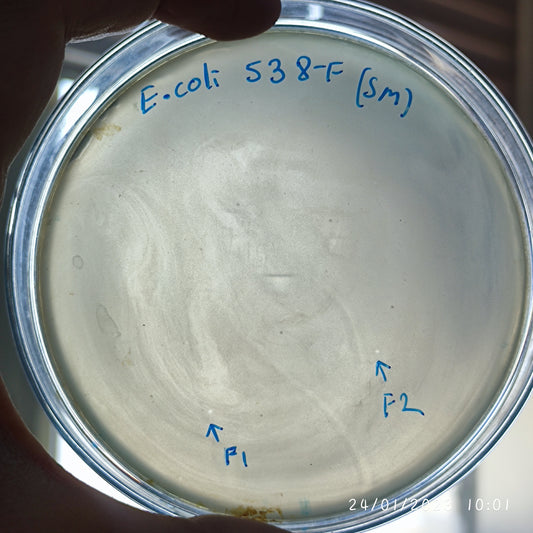
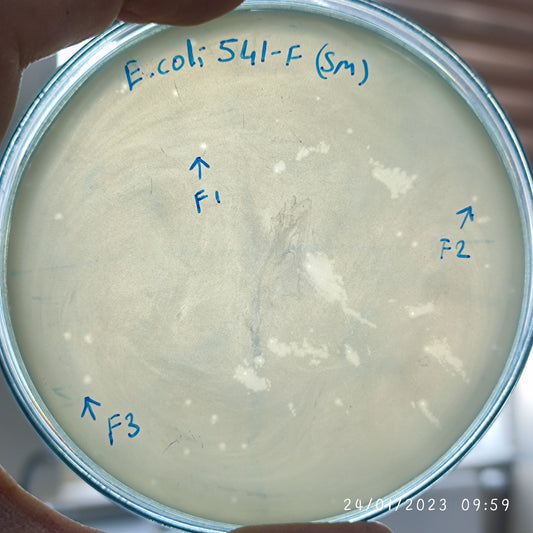
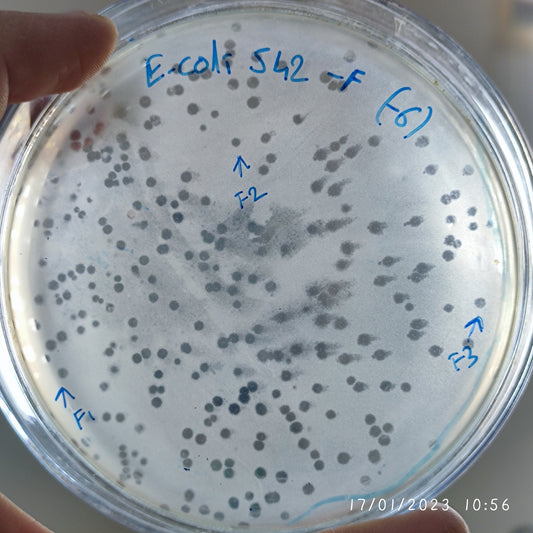
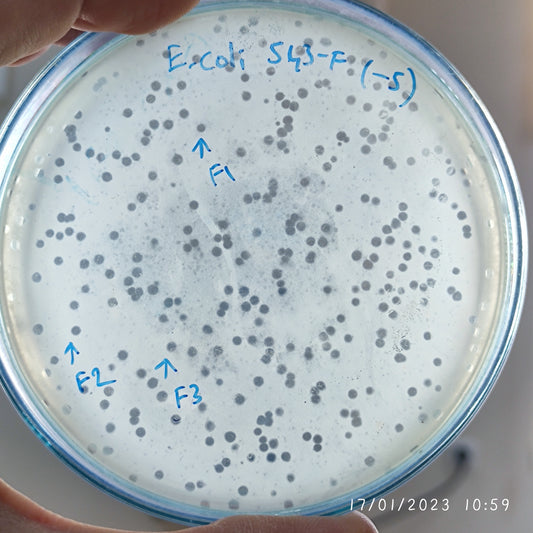
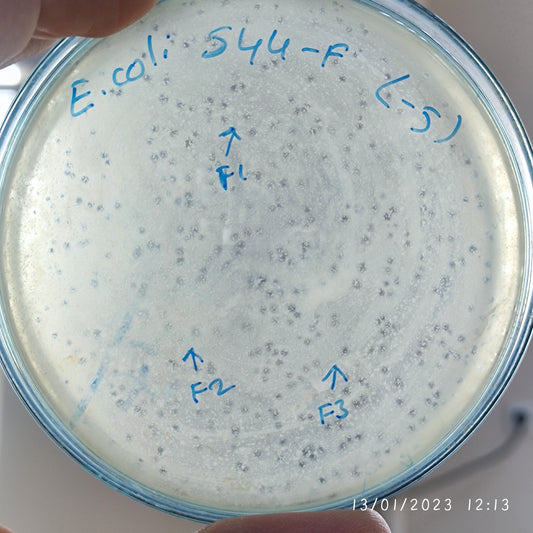
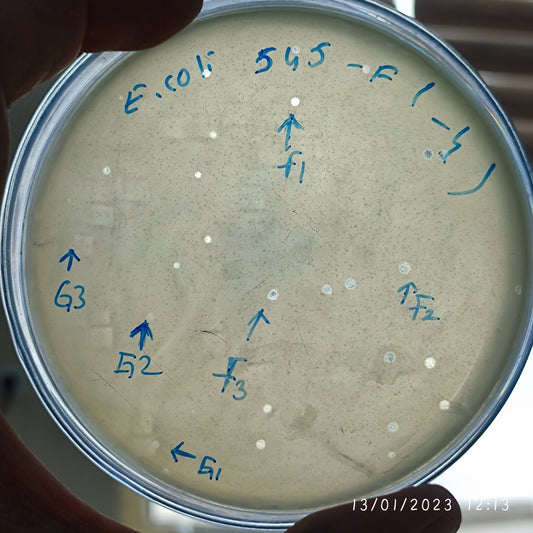

-
Escherichia coli bacteriophage 100529F
Regular price $500.00 USDRegular priceUnit price per -
Escherichia coli bacteriophage 100530F
Regular price $400.00 USDRegular priceUnit price per -
Escherichia coli bacteriophage 100531F
Regular price $0.00 USDRegular priceUnit price per -
Escherichia coli bacteriophage 100532F
Regular price $400.00 USDRegular priceUnit price per -
Escherichia coli bacteriophage 100533F
Regular price $500.00 USDRegular priceUnit price per -
Escherichia coli bacteriophage 100534F
Regular price $750.00 USDRegular priceUnit price per -
Escherichia coli bacteriophage 100536F
Regular price $600.00 USDRegular priceUnit price per -
Escherichia coli bacteriophage 100537F
Regular price $500.00 USDRegular priceUnit price per -
Escherichia coli bacteriophage 100538F
Regular price $500.00 USDRegular priceUnit price per -
Escherichia coli bacteriophage 100539F
Regular price $900.00 USDRegular priceUnit price per -
Escherichia coli bacteriophage 100541F
Regular price $750.00 USDRegular priceUnit price per -
Escherichia coli bacteriophage 100542F
Regular price $500.00 USDRegular priceUnit price per -
Escherichia coli bacteriophage 100543F
Regular price $500.00 USDRegular priceUnit price per -
Escherichia coli bacteriophage 100544F
Regular price $500.00 USDRegular priceUnit price per -
Escherichia coli bacteriophage 100545F
Regular price $500.00 USDRegular priceUnit price per -
Escherichia coli bacteriophage 100545G
Regular price $500.00 USDRegular priceUnit price per